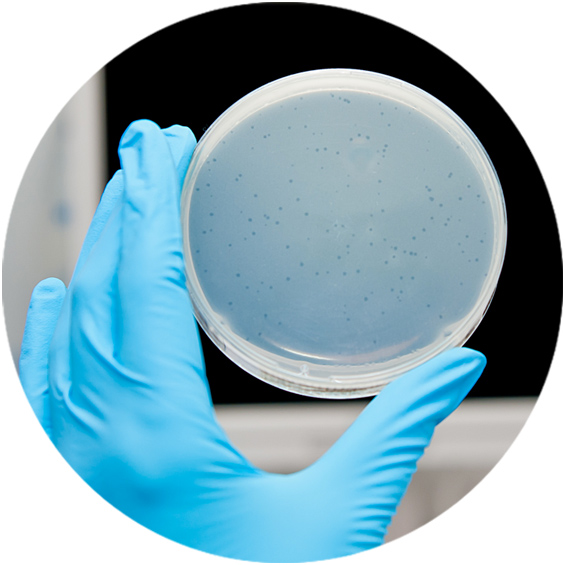

Water Viral Indicators
Persistence of bacteriophages
Bacteriophages tend to persist in the environment and are moderately resistant to natural and anthropogenic stressors. They can only replicate inside susceptible host bacteria. A given bacteriophage can only infect certain bacteria to the point that different strains of the same species differ in their susceptibility to bacteriophage attack. Somatic and F- specific coliphages (bacteriophages infecting coliform bacteria such as E.coli) are excellent indicators because they usually persist longer than bacteria in the environment. When there are coliphages, other viruses can be present in the environment but with lower concentrations. So, monitoring through this viral indicator can prevent some diseases related to human viruses.


Size and presence of bacteriophages
In general, bacteriophages are viruses that infect bacteria and are extremely abundant in nature, probably the most abundant life form on Earth.
In particular, bacteriophages outnumber bacteria in most habitats studied including microbial communities associated with humans and animals.
In a facility with filters, membranes or other technology, monitoring of bacteriophages provides greater safety than that of bacteria, due to their size (bacteriophages being smaller than bacteria) and greater abundance.
Coliphages as a water viral indicator
Many viruses are present in a fecal contamination, including norovirus, VHA, rotavirus, and adenovirus. It is complicated and expensive to analyze all types of virus, and for this reason it is necessary to select a virus as an indicator that shows the presence of the others. The indicator is good when its presence is higher and it is easier to enumerate than other viruses. Coliphages are used as fecal indicators as they mimic enteric viruses better than any other group of indicators since they fulfill these conditions, and show moderate resistance and persistence in the water environment and through wastewater treatment.
The appeal of phages as indicators lies in the availability of feasible, fast and cost-effective detection methods, and their abundance in wastewaters of human and animal origin. Moreover, samples can be kept at 4ºC for at least 48 hours without any significant change in the numbers of infectious coliphages and small samples can be kept for months at -20ºC or -80ºC after the addition of 10% v/v glycerol.
Reference suspensions of coliphages needed for quality assurance are easily prepared and conserved. Finally, phenomena such as stress, injury or reactivation that frequently lead to misinterpretation of environmental data derived from bacterial indicators do not affect coliphages.
The method of detection of infectious coliphages is through their effects, mostly lysis, on the host bacteria that they infect.